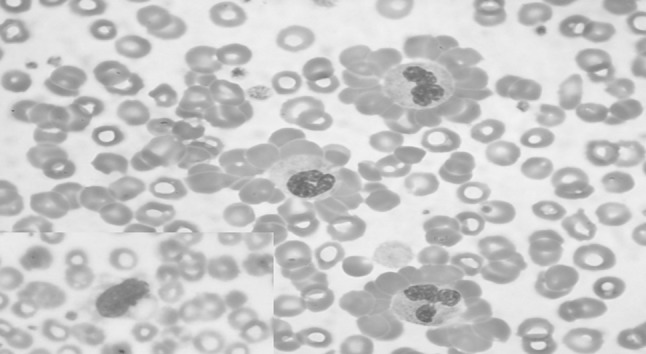
Fig. 1

Dear Editor,
Presence of spherocytes and or red cell agglutination in blood smear are pathognomonic of autoimmune haemolytic anemia (AIHA) [1]. An unusual and infrequent manifestation of AIHA is rosetting of leucocytes by red blood cells (RBC’s), more commonly documented with monocytes. Here we describe a case of AIHA on treatment where peripheral blood smear examination showed the presence of numerous neutrophil-erythrocyte rosettes.
A 43 year old male presented with complaints of episodes of jaundice, mild fever and generalized body ache of 20 days duration. He also complained of episodic passage of reddish colour urine since 20 days. The patient had a past history of similar complaints 5 years back, when he was diagnosed to have AIHA and was treated with prednisolone at a dose of 35 mg/day, which was gradually tapered off. Examination revealed pallor and icterus with mild hepatosplenomegaly. Investigations showed haemoglobin of 9.9 gm/dl, corrected reticulocyte count of 5.8 %, serum total and conjugated bilirubin of 2.6 and 1.0 mg/dl respectively. Plasma haemoglobin and serum lactate dehydrogenase were elevated measuring 62.8 mg/L and 1296 U/L, respectively. Urine routine examination was positive for protein, bilirubin and blood/haemoglobin (2+), while microscopic examination showed only 2–3 RBC’s per high power field. Peripheral blood smear showed frequent RBC rosettes around neutrophils (Fig. 1). All the rosettes were typically seen with neutrophils and none around monocytes (inset Fig. 1). Direct antiglobulin test was strongly positive for IgG and C3d complement (4+). The patient was re-initiated on prednisolone at a dose of 35 mg/day.
Fig. 1.
May Grunwald Giemsa stained peripheral blood smear showing presence of numerous neutrophil erythrocyte rosettes (×400) and inset showing presence of a monocyte without RBC rosetting
Red cell-neutrophil rosettes are rarely described in AIHA [2]. Though the rosettes have been proposed to represent a physiologic intermediate in extravascular RBC destruction and strongly predict clinical AIHA, the exact mechanism behind the rosette formation is unclear. Shaw et al. in 1979, performed in vitro studies utilizing antibody coated RBC’s and clearly demonstrated that the Fc receptors, present on all three cell types namely neutrophils, monocytes and lymphocytes interact with the antibody coated red cells and result in rosette formation. The antibody dependant cell cytotoxicity was found to be much more by monocytes than neutrophils, thereby indicating that neutrophils require a much higher titre of antibody coated target cells to mediate cytotoxicity [3]. The presence of these rosettes in this patient were possibly due to interaction of neutrophil Fc receptors with the IgG decorated RBC’s, though interestingly, no such rosettes could be appreciated with monocytes. Moreover, this rosetting is distinct from the red cell clumping seen in cold antibody disease, which is mediated by the interaction of the pentameric IgM antibody with I/i antigen on the RBC’s [1]. Similar neutrophil erythrocyte rosettes have also been described in EDTA anticoagulated blood samples [4].
The clinical relevance of these rosettes is elusive, yet their presence in peripheral smears can be considered as indicator of an ongoing auto immune process. These interactions may contribute to intravascular hemolysis, especially when the titre of the antibodies is very high, as demonstrated in the cytotoxicity in vitro studies by Shaw et al. [3].
Acknowledgments
Conflict of interest
The authors would like to state there is no conflict of interest.
Contributor Information
Geeta Yadav, Email: euphoricgeeta@gmail.com.
Khaliqur Rahman, Email: drkhaliq81@gmail.com.
Ruchi Gupta, Email: ruchipgi@yahoo.co.in.
References
- 1.Zeerleder S. Autoimmune haemolytic anaemia - a practical guide to cope with a diagnostic and therapeutic challenge. Neth J Med. 2011;69(4):177–184. [PubMed] [Google Scholar]
- 2.Schulman S, Awad MM, Kuter DJ. Neutrophil-erythrocyte rosettes in autoimmune hemolytic anemia. Am J Hematol. 2013;88(4):333–334. doi: 10.1002/ajh.23277. [DOI] [PubMed] [Google Scholar]
- 3.Shaw GM, Levy PC, Lobuglio AF. Re-examination of the EA rosette assay (Ripley) for Fc receptor leucocytes. Clin Exp Immunol. 1979;36(3):496–501. [PMC free article] [PubMed] [Google Scholar]
- 4.Pettit JE, Scott J, Hussein S. EDTA dependent red cell neutrophil rosetting in autoimmune haemolytic anaemia. J Clin Pathol. 1976;29(4):345–346. doi: 10.1136/jcp.29.4.345. [DOI] [PMC free article] [PubMed] [Google Scholar]
